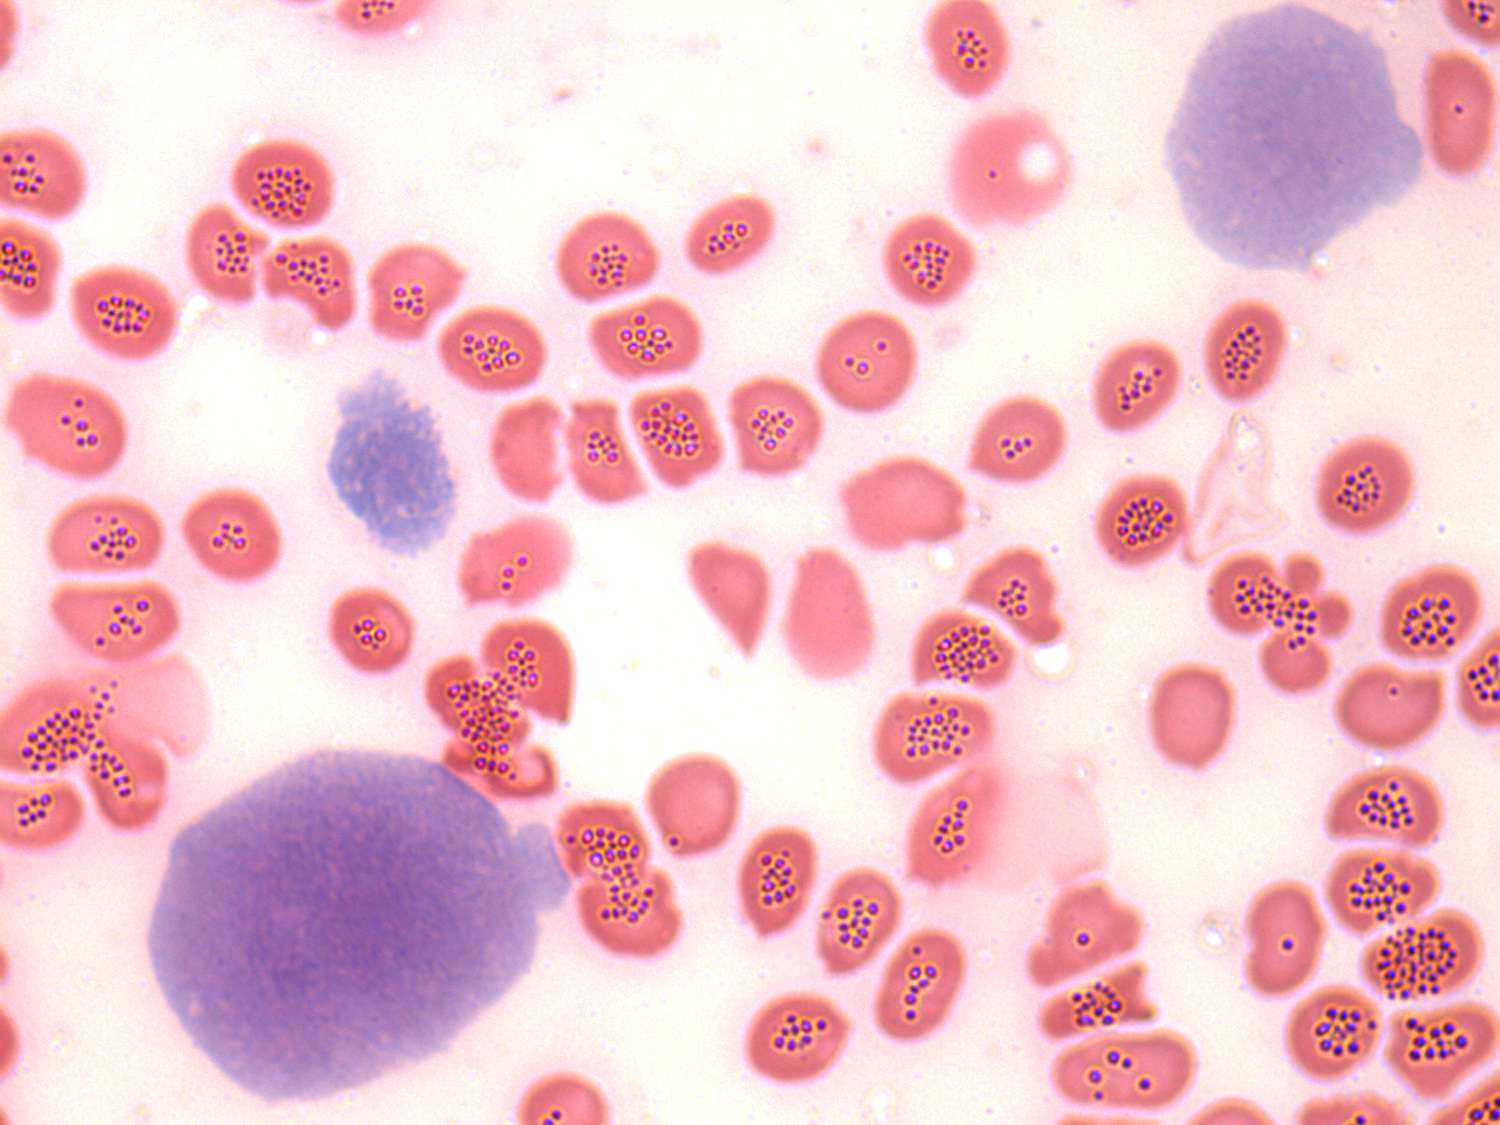

Anaplastic carcinoma - Figure 4. Cytological properties - only a few cells are on the smear.
Necrosis is a frequent finding therefore gaining adequate material for microscopic analysis is often a difficult task. If we are aware about the clinical presentation, cytological diagnosis can be made on the presence of only a few atypical, pleomorphic cells.
 |
|
 |
 |